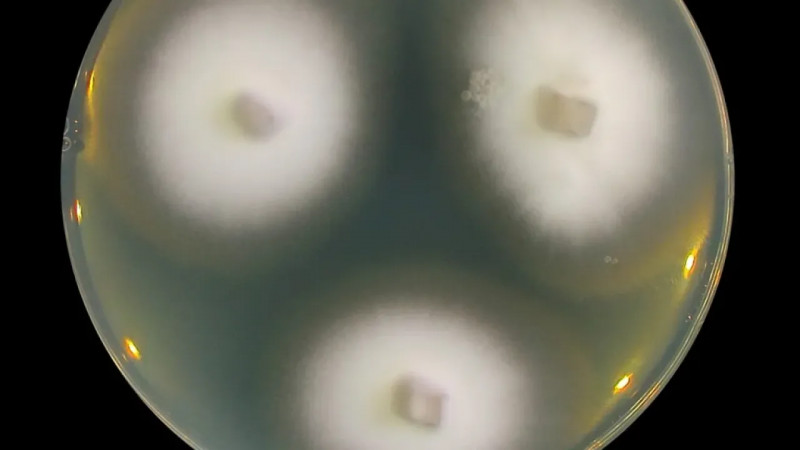
Link Preview

ČT24 - Nejdůvěryhodnější zpravodajský web
News sourceV USA probíhá další vlna protestů pod názvem No Kings, zaměřená proti prezidentu Trumpovi a jeho autoritářským tendencím, s více než 3200 plánovanými akcemi napříč padesáti státy a městy, které vyjadřují hněv po nedávných incidentech s imigračními agenty, přičemž očekávaným vrcholem je velká demonstrace v Minnesotě s účastí hvězd jako Bruce Springsteen a Joan Baezová. #Protesty #Demokracie #Trump

Nová varianta covidu-19, označovaná jako cikáda (BA.3.2), se šíří i v Česku a vyznačuje se mutacemi, které mohou snižovat účinnost protilátek získaných očkováním a předchozí infekcí, což vyžaduje monitorování a případnou změnu v očkovacích strategiích. #covid19 #SARSCoV2 #očkování

Ukrajině hrozí, že do dvou měsíců dojdou finance na obranu proti ruské agresi kvůli blokaci evropské půjčky a nedostatku zahraniční pomoci, což komplikuje její schopnost vyplácet vojáky a kryt nezbytné výdaje. #Ukrajina #obrana #financování

Izrael oznámil, že poprvé během současné války na Blízkém východě zaznamenal odpálení rakety z Jemenu, přičemž jemenské hútíové se vyjádřili, že jsou připraveni reagovat na pokračující eskalaci proti Íránu a jeho spojencům, což by mohlo rozšířit konflikt do nové oblasti. #BlízkýVýchod #konflikt #hútíové

Izrael rozšiřuje svou nárazníkovou zónu v jižním Libanonu, což vyvolává obavy libanonské vlády o suverenitu a bezpečnost země, která zároveň čelí vnitřním rozporům a žádá OSN o zásah, přičemž situace naznačuje rozdělení v libanonské společnosti a neschopnost politiků jednat efektivně vůči Hizballáhu. #Izrael #Libanon #politika

Film poukazuje na volební manipulace v Maďarsku, kde podle svědectví osobností z různých žup Fidesz využívá ke kupčení s hlasy peníze, hrozby a závislost voličů na svých představených, což zahrnuje například poskytování léků či dřeva pouze pro podporovatele strany, a dokonce i organizovaný odvoz k volebním místnostem. #Volby #Maďarsko #Fidesz

Vědci testují novou očkovací látku proti fentanylu, aby blokovali jeho účinky a čelili tak epidemii závislosti, která každý rok ve Spojených státech připravuje o život přes 70 tisíc lidí. #fentanil #závislost #vakcína

Evropané se snaží přesvědčit amerického ministra Rubio, aby ukončil válku proti Íránu, zatímco v současném konfliktu již zahynulo přes devatenáct set lidí a Spojené státy s Izraelem zahájily vzdušné útoky, přičemž Trump čelí kritice za nejasné cíle americké intervence. #Írán #Válka #Politika

Experti varují, že se blíží super El Niño, což by mohlo vést k nejteplejšímu roku v historii a výrazně ovlivnit počasí na mnoha místech světa. #ElNiño #klima #počasí

Španělka, trpící paraplegií a vážnou nemocí, podstoupila eutanazii, přestože její otec proti tomu vedl dlouhou právní bitvu, která skončila neúspěšně, a to i po odmítnutí Evropského soudu pro lidská práva zasáhnout, což umožnilo provedení zákroku. #eutanazie #lidskápráva #duševnízdraví

Rozsudek proti Metě a Googlem odhaluje nedostatky v regulaci technologií podobně jako v tabákovém průmyslu, zatímco Apple čelí žalobě za omezení přístupu k třetím stranám v App Storu a TikTok se potýká s obviněními ohledně ochrany uživatelských dat, přičemž whistleblowing, včetně odhalení Frances Haugenové, vrhá světlo na problematické praktiky velkých technologických firem. #Apple #whistleblowing #technologie

Německo plánuje splnit své klimatické cíle výstavbou 2000 větrných elektráren a podporou elektromobility s cílem ušetřit 27,1 milionu tun oxidu uhličitého do konce desetiletí, přičemž na tento program uvolní osm miliard eur, ačkoli někteří kritici považují strategii vlády za příliš optimistickou a vycházející ze zastaralých dat. #elektromobilita #ochranaklimatu #udrzitelnost #dobrezpravy

Výzkum ukázal, že konzumace ultrazpracovaných potravin může negativně ovlivnit plodnost, přičemž u mužů se prokazatelně zvyšuje riziko snížené plodnosti a delší doby k dosažení těhotenství, zatímco u žen byly zaznamenány malé odchylky ve vývoji embrya, což podtrhuje význam stravy pro zdraví matek i dětí. #ultrazpracovanépotraviny #zdraví #plodnost

V ruském přístavu Usť-Luga vypukl požár po dronovém útoku, zatímco Rusko reagovalo útoky na Ukrajinskou energetickou infrastrukturu, což vedlo k výpadkům proudu pro statisíce lidí v obou zemích. #Rusko #Ukrajina #Drony

Výzkum usazenin na dně Špicberků odhalil značné množství mikroskopického života, včetně bakterií s geny odolnými vůči antibiotikům, což naznačuje možnost vzniku 'superbakterií' v arktickém prostředí. #Mikrobiologie #AntibiotickáOdolnost #OceánskýŽivot

Studie z Imperial College v Londýně zjistila, že děti trávící na sociálních sítích více než tři hodiny denně mají vyšší pravděpodobnost budoucí deprese a úzkosti, což je pravděpodobně způsobeno nedostatkem spánku způsobeným používáním těchto médií v noci, přičemž tento vliv je výraznější u dívek. #SociálníSítě #DuševníZdraví #Děti

Nový výzkum ukazuje, že změny klimatu mohou českým zemědělcům přinést příležitosti ke zvýšení výnosů a rozšíření pěstebních ploch, pokud se přizpůsobí globálním tržním podmínkám a novým klimatickým výzvám, přičemž důležitá je adekvátní příprava. #klimatickázměna #zemědělství #globálníobchod

Studie o sovětské ponorce ztroskotané u Norska odhalila zvýšené úniky radiace, přičemž moderní výzkum potvrdil, že dřívější sanační opatření Ruska stále ovlivňují situaci, přičemž koncentrace radioaktivity v okolních vzorcích dosahovala až 800tisíckrát vyšších hodnot než obvyklé normy. #radioaktivita #výzkum #jadernétechnologie

Ruský útok přerušil klíčové elektrické vedení mezi Moldavskem a Rumunskem, což vedlo k rozsáhlému výpadku dodávek elektřiny v Moldavsku a vyhlášení stavu nouze, zatímco země se snaží zbavit závislosti na dodávkách elektřiny z proruského regionu Podněstří. #Energetika #Moldavsko #Ukrajina

Čína úspěšně proměňuje okraje pouště Taklamakan v zalesněné oblasti, jež již nyní pohlcuje více oxidu uhličitého, než kolik ho produkuje, díky téměř padesátiletému programu výsadby stromů, jak dokládá nová studie publikovaná v odborném časopise PNAS. #ekologie #zalesňování #klimatická změna #dobrezpravy

Izrael provedl další útok na most v Libanonu s cílem izolovat jižní oblast země, přičemž podle zpráv byl použit bílý fosfor, což je v rozporu se Ženevskou konvencí, zatímco střety s militantním hnutím Hizballáh pokračují, přičemž izraelské bombardování si od 2. března vyžádalo 1029 mrtvých, včetně 118 dětí. #Izrael #Libanon #válka

Světová meteorologická organizace varuje, že se klima vychyluje z rovnováhy, protože koncentrace skleníkových plynů dosáhly historicky nejvyšších úrovní a energetická nerovnováha Země se stále zhoršuje, což má vážné důsledky pro budoucnost planety. #klimatickázměna #oteplování #energetickánerovnováha

V Íránu se šíří houbový patogen Trichophyton mentagrophytes var. indotineae, který odolává běžné léčbě a hrozí jeho rozšíření do Evropy, přičemž česká mikrobioložka Adéla Wennrich a její tým usilovně zkoumají tento virus, aby se připravili na potenciální epidemii. #houbovéinfekce #věda #zdraví
Britská policie vyšetřuje požár čtyř sanitek, které patřily židovské organizaci Hatzolah, jako antisemitský trestný čin, přičemž britský premiér a ministr zdravotnictví odsoudili tento činy jako projev nenávisti, zatímco hasiči museli evakuovat okolí kvůli výbuchu tlakových lahví. #antisemitismus #hnusnéčiny #školenínávisti

Izrael znovu zaútočil na Teherán, při němž došlo k útoku na jihoíránský vysílač s jednou obětí, zatímco americký prezident Trump dal Íránu 48hodinové ultimátum k otevření Hormuzského průlivu, jinak hrozí útoky na íránské elektrárny, což vyvolalo odvetná varování ze strany Íránských revolučních gard. #HormuzskýPrůliv #EnergetickáBezpečnost #MezinárodníVztahy

V Číně pokračují čistky v armádním sektoru, kdy bylo odvoláno nebo vyšetřováno 37 generálů a na nedávném parlamentním zasedání se zúčastnilo pouze šest generálů, přičemž podle amerických rozvědek Peking neplánuje invazi na Tchaj-wan, i když zvyšuje tlak na ostrov častými válečnými manévry. #Čína #Tchaj-wan #obrana

Zelenskyj vyjádřil naději na další výměny zajatců a upozornil, že Putin nechce ukončit válku, zatímco americký zmocněnec oznámil konstruktivní jednání na Floridě zaměřená na bezpečnostní záruky a humanitární otázky. #diplomacie #výměnazajatců #mírovájednání

Maďarský ministr zahraničí Péter Szijjártó údajně během jednání EU pravidelně telefonicky informoval Rusko o průběhu vyjednávání, což podle The Washington Post umožnilo Moskvě být v podstatě přítomna na většině zasedání unie, zatímco většina ostatních evropských lídrů se od začátku ruské invaze na Ukrajinu do Moskvy nevydala. #EU #Rusko #diplomacie

Při havárii vojenského vrtulníku v Kataru zahynulo nejméně šest lidí, přičemž resort obrany neuvedl národnost obětí, zatímco v regionu probíhá konflikt mezi Izraelem a Spojenými státy proti Íránu, což vedlo k výraznému snížení výroby zkapalněného zemního plynu v Kataru a globálním výpadkům dodávek této suroviny. #Blízkovýchod #konflikt #vojenskéúdery

Analytik Jan Šír upozornil na tvrdé potlačování odpůrců v současném Rusku, které podle něj překonává praktiky sovětské éry a zahrnuje zavírání disidentů do psychiatrických léčeben, zatímco přístup k nezávislým informacím, jako jsou válečné statistiky, je značně ztížen a trestně postižitelný. #RepresivníRežimy #SvobodaSlova #PsychiatrickéPraktiky

Na pražské Letné v sobotu odpoledne začalo shromáždění iniciativy Milion chvilek s názvem Nenecháme si ukrást budoucnost, jehož cílem je varovat před erozí demokracie a vládními kroky Andreje Babiše, přičemž organizátoři očekávají účast 200 až 400 tisíc lidí, včetně významných osobností, a plánují zajištění bezpečnosti a zdravotní péče na místě. #demokracie #protest #společnost

Íránská armáda obvinila USA a Izrael z útoku na íránská zařízení na obohacování uranu a zároveň odpálila balistické střely na americko-britskou základnu na atolu Diego García, přičemž žádná ze střel cíl nezasáhla, což naznačuje, že Írán má rakety s větším dostřelem, než Západ předpokládal. #Írán #BezpilotníLetouny #BalistickéStřely

Klimatické změny ohrožují antické památky, jako je starověká Olympie, a řecká historička Sophia Zoumbakiová varuje, že se můžeme poučit z historie tohoto místa, které bylo zapomenuto pod nánosy bahna a jehož ochranu je třeba zajistit vůči současným klimatickým hrozbám. #KlimatickáZměna #AntickéPamátky #OlympijskéHry

Ruské úřady v Mariupolu se snaží zakrýt zločiny okupantů obnovou zničeného divadla, přičemž zbytky obětí bombardování mohly zůstat pohřbeny v základech nové budovy, jak naznačují svědectví místních obyvatel a novinářů. #Mariupol #ruskýútok #obnova

Americký prezident Donald Trump označil spojence v NATO za zbabělce, protože odmítají pomoci s obnovením bezpečné plavby v Hormuzském průlivu, přičemž kritizoval jejich stížnosti na vysoké ceny ropy, zatímco malá skupina evropských států spolu s Japonskem vyjádřila ochotu se podílet na zajištění bezpečnosti v oblasti po americko-izraelských útocích na Írán. #NATO #HormuzskýPrůliv #MezinárodníPolitika

Íránci žijí ve stálém strachu a beznaději ve válce s Izraelem a Spojenými státy, přičemž tisíce lidí opustily své domovy a i ti, kdo původně usilovali o změnu režimu, nyní pochybují o budoucnosti země zasažené každodenními bombardováními a brutálními zásahy bezpečnostních sil. #Iran #War #HumanRights

Izraelský útok na plynové pole v Perském zálivu, který podle Trumpa nebyl schválen Spojenými státy, vyvolal širokou kritiku, a izraelské média tvrdí, že operace měla souhlas Washingtonu, přičemž Trump varoval před silnými odvetnými akcemi proti Íránu v případě dalších útoků na Katar. #Izrael #PlynovéPole #PerskýZáliv

Ceny ropy nadále rostou, překonávají 113 dolarů za barel, v důsledku útoků na energetickou infrastrukturu v Blízkém východě, přičemž důležitý exportní přístav v Rudém moři byl terčem vzdušného úderu, jehož dopad je podle zdrojů minimální. #ropa #energetika #konflikt

Novináři objevili identitu Banksyho, avšak jeho okolí a právníci apelují na to, aby nebyla zveřejněna, neboť by to mohlo ohrozit umělcovu anonymitu, svobodu projevu a bezpečnost, což je pro jeho dílo i veřejný zájem zásadní. #Banksy #anonymita #umění

Celníci rozkryli mezinárodní drogovou skupinu a zabavili rekordní zásilku 115 kilogramů ketaminu, která směřovala do Kanady a mohla na tamním trhu dosáhnout hodnoty 250 milionů korun, přičemž tři podezřelí cizinci čelí trestnímu stíhání a hrozí jim až osmnáctileté vězení. #drogy #pašování #celníci

Virus chikungunya se díky oteplování a šíření komárů může začít rozšiřovat do Evropy, včetně Česka, kde by případy nákazy mohly být častější zejména v létě a v důsledku klimatické krize i po delší období. #Chikungunya #KlimatickáKrizе #Zdraví

V CERNu byla potvrzena existence nové částice nazvané Xi-cc-plus, která je považována za obtloustlého bratrance protonu a byla poprvé zaznamenána v datech před více než dvaceti lety, přičemž její objev přinesl nové poznatky o netypických vlastnostech elementárních částic. #fyzika #věda #částice

Vyšetřovatelé potvrdili, že Rusko systematicky deportuje ukrajinské děti a zajišťuje jejich dlouhodobé umístění v ruských rodinách či institucích, přičemž mnozí rodiče stále neznají osud svých dětí, které často dostávají ruské občanství a jsou zařazovány do databází pro adopci, což poukazuje na organizovaný a státem řízený plán zvnitřnění dětí od doby před invazí na Ukrajinu. #UkrajinskéDěti #Deportace #LidskáPráva

Francouzské Nice se intenzivně připravuje na možnou hrozbu tsunami, která, ačkoliv jsou ve Středozemním moři vzácné, může způsobit vážné škody, a podle výzkumů existuje vysoké riziko jejich výskytu v příštích třiceti letech. #Tsunami #Středomoří #Rizika

Íránská íránistka Lenka Hrabalová upozorňuje, že útoky USA a Izraele ničí památky v Íránu, což využívá tamní režim k obraně kulturních skvostů, zatímco ministerstvo kultury hlásí vážné škody na 56 muzeích a památkách, přičemž označuje tato místa modrými štíty podle Haagské úmluvy, avšak izraelská armáda tvrdí, že na kulturní památky cíleně neútočí. #Kultura #Památky #Válka

Členské státy EU a Evropský parlament se neshodly na prodloužení prozatímního nařízení umožňujícího platformám skenovat komunikaci uživatelů kvůli dětské pornografii, což může vést k vymizení této kontroly po vypršení nařízení 3. dubna. #EU #dětství #ochrana_dětí

Einsteinův teleskop, extrémně citlivý gravitační dalekohled, jehož výstavba v blízkosti českých hranic si vyžádá 61 miliard korun, slibuje revoluční pozorování vzniku galaxií a vývoje vesmíru po Velkém třesku s možností zachytit tisíckrát více srážek černých děr a neutronových hvězd než stávající observatoře, a zároveň představuje příležitost pro české firmy a vědeckou komunitu. #Vesmír #GravitačníVlny #Astronomie

Ukrajinci v rámci cvičení NATO REPMUS/Dynamic Messenger 2025 v Portugalsku dokázali díky mezinárodnímu týmu najít slabá místa v obraně námořních sil Aliance, když potopili alespoň jednu fregatu a porazili síly NATO ve všech pěti testovacích scénářích. #NATO #Ukrajina #vojenskécvičení

Umělá inteligence zásadně mění obraz války na sociálních sítích, kde se vedle autentických videí z konfliktu objevují falešné či generované snímky s milionovými dosahy, což ovlivňuje veřejné vnímání událostí a je využíváno jako součást informační války. #UměláInteligence #Dezinformace #MediálníVálka

V městě Maiduguri na severovýchodě Nigérie došlo k sérii výbuchů, které si vyžádaly nejméně 23 obětí a 108 zraněných, přičemž policie vyšetřuje možné sebevražedné bombové útoky. #Maiduguri #BombovýÚtok #Bezpečnost


